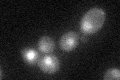
YIL101C
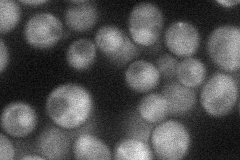
YIL101C
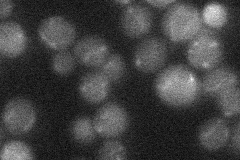
YIL101C

View description
Transcriptional repressor that binds to promoter sequences of the cyclin genes, CYS3, and SMF2; expression is induced by stress or starvation during mitosis, and late in meiosis; member of the Swi4p/Mbp1p family; potential Cdc28p substrate
Localization:
Intensity:
Fold change:
Significance:
-
C’ GFP library in SD
nucleus22.49 -
N' NOP1pr-GFP in SD
cytosol,nucleus27.1857 -
N' TEF2pr-mCherry in SD

below threshold22.5391 -
N' NATIVEpr-GFP in SD
below threshold18.4984 -
N' TEF2pr-VC and Cyto-VN in SD

below threshold23.5924 -
C’ GFP library in SD+DTT

nucleus28.141.25No -
C’ GFP library in SD+H2O2

nucleus28.141.25No -
C’ GFP library in Starvation Media

nucleus49.912.21Yes -
C’ GFP library on the background of Pup2-DaMP

nucleus -
C’ GFP library on the background of CCT mutant

nucleusN/AN/ANo
